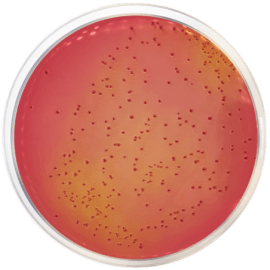
main product photo

Close
MACCONKEY AGAR WITH SORBITOL 500 grams/bottle
SKU
CDL/1099
Brand
CONDALAB
Pre-order (Deliver in 8 to 12 weeks)
MacConkey Agar with Sorbitol (CT-SMAC) is based on the formula developed by Rappaport & Hening. This medium is recommended for the research of E. coli O157:H7 in clinical and food testing. The composition is similar to MacConkey Agar (Cat. 1052) but the lactose has been substituted with sorbitol for differentiating enteropathogenic E. coli serotypes. These strains are typically sorbitol-negative. On standard MacConkey Agar containing lactose, this strain cannot be distinguished from other lactose fermenting E. coli.
Gelatin peptone provides nitrogen, vitamins, minerals and amino acids essential for growth. Sorbitol is the carbohydrate energy source. Bile salts N �3 and Crystal violet are inhibitors of Gram-positive organisms. Sodium chloride supplies essential electrolytes for transport and osmotic balance. Neutral red is the pH indicador, when sorbitol is fermented, the pH of the medium decreases, changing the color from neutral red to pink. Bacteriological agar is the solidifying agent.
E. coli O157:H7 does not ferment Sorbitol and therefore produces colorless colonies. As most of the other E. coli do ferment it, their colonies are pink.
E. coli O157:H7 has become a widespread public health issue as it is responsible for hemorrhagic colitis, characterized by a bleeding diarrhea with acute abdominal pain. Incorrect antibiotic treatment may increase the risk of haemolytic uraemic syndrome development, a potentially fatal complication of this form of colitis.
MacConkey Agar with Sorbitol (CT-SMAC) is based on the formula developed by Rappaport & Hening. This medium is recommended for the research of E. coli O157:H7 in clinical and food testing. The composition is similar to MacConkey Agar (Cat. 1052) but the lactose has been substituted with sorbitol for differentiating enteropathogenic E. coli serotypes. These strains are typically sorbitol-negative. On standard MacConkey Agar containing lactose, this strain cannot be distinguished from other lactose fermenting E. coli.
Gelatin peptone provides nitrogen, vitamins, minerals and amino acids essential for growth. Sorbitol is the carbohydrate energy source. Bile salts N º3 and Crystal violet are inhibitors of Gram-positive organisms. Sodium chloride supplies essential electrolytes for transport and osmotic balance. Neutral red is the pH indicador, when sorbitol is fermented, the pH of the medium decreases, changing the color from neutral red to pink. Bacteriological agar is the solidifying agent.
E. coli O157:H7 does not ferment Sorbitol and therefore produces colorless colonies. As most of the other E. coli do ferment it, their colonies are pink.
E. coli O157:H7 has become a widespread public health issue as it is responsible for hemorrhagic colitis, characterized by a bleeding diarrhea with acute abdominal pain. Incorrect antibiotic treatment may increase the risk of haemolytic uraemic syndrome development, a potentially fatal complication of this form of colitis.
| Brand | CONDALAB |
|---|
Write Your Own Review

Validate your login